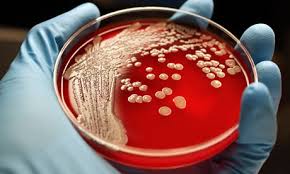

antibiotiká
-

Antibiotiká spôsobujú mutovanie a 4 násobné množenie nebezpečných baktérií
Väčšina ľudí, žiaľ vrátane väčšiny lekárov, stále podceňuje varovanie expertov o rastúcom nebezpečenstve zlyhávania antibiotík. Nová štúdia zistila,…
-

Ako sa vyhnúť vybratiu mandlí – jednoduchý a účinný protokol
Napriek tomu, že na západe lekári odporúčajú odstránenie mandlí len vo vážnych prípadoch, na Slovensku sú…
-

Antibiotiká môžu vážne poškodiť dieťa
Opakované užívanie antibiotík v rannom detstve môže spôsobiť obezitu, prílišný rast kosti a zapríčiniť zmenu črevných…
-

Zdravé črevá a ich význam v boji proti infekciám ako kandida
Narušená rovnováha v črevnej mikroflóre môže spôsobiť vážne, často životunebezpečné infekcie, vedúce k otrave krvi. Nerovnováhu v črevách…
-

Infekcie močových ciest a liečba bez antibiotík
Podľa štúdie z roku 2013 publikovenaj v časopise BMC Family Practice voľne dostupnom v medicínskej databáze BioMed Central,…
-

Dievča malo fatálnu alergickú reakciu po čučoriedkách. Kvôli antibiotikám
10 ročné dievča malo fatálnu alergickú reakciu po zjedení čučoriedok. Vyšetrovanie zistilo, že alergická reakcia nebola…
-
Medicína prehráva vojnu s baktériami
Nová generácia superbaktérií, ktorá je odolná voči najmodernejším antibiotikám, môže vykynožiť desiatky tisíc ľudí postihnutých bežnými…
-

Ako som vyliečila dve deti s akútnymi zápalmi – bez antibiotík!
Milí priatelia, Deti sú v súčasnosti veľmi choré. Denne nám prichádzajú emaily od mnohých rodičov s…
-

Antibiotiká u kojencov môžu vyvolať astmu a prejavy alergie
Podávanie antibiotík kojencom, ktorí ešte nedovŕšili 6 mesiacov, môže zvýšiť riziko astmy až o viac ako…